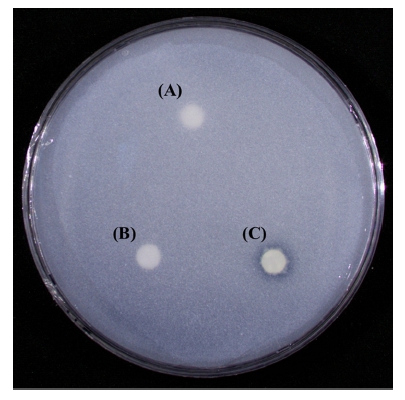
Fig. 4.
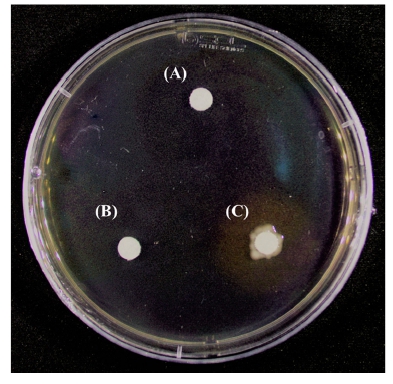
Fig. 5.

일천궁에서 분리한 근권 내생 미생물의 식물생육증진 효과
This is an open access article distributed under the terms of the Creative Commons Attribution Non-Commercial License (http://creativecommons.org/licenses/by-nc/3.0/) which permits unrestricted non-commercial use, distribution, and reproduction in any medium, provided the original work is properly cited.
Abstract
This study was conducted to evaluate the plant growth promoting effect of rhizobacterial endophytes on Cnidium officinale Makino cultivated in Korea.
Twenty-four rhizobacterial were isolated from C. officinale Makino, and the L2 strain observed to have excellent plant growth promotion ability. Based on 16s rRNA sequence analysis, L2 was identified as Enterobacter ludwigii. The selected endophyte was evaluated for indole-3-acetic acid (IAA), siderophore, phosphate solubilizing assay, and extracellular enzyme activity to determine the growth promoting effect of the strain on C. officinale Makino under pot conditions. L2 produced IAA and siderophore and exhibited phosphate solubilizing activity. L2 was inoculated to the pot to evaluate the growth of C. officinale Makino. The shoot fresh weight and rhizome dryweight of C. officinale Makino inoculated with L2 after 5 weeks were higher than those of control samples.
This study suggests that rhizobacterial endophytes can be used as a growth promoter and may be a potential for biofertilizer in the cultivation of Cnidium officinale Makino.
Keywords:
Cnidium officinale Makino, Enterobacter ludwigii, Effective Microorganism, Endophytes, Indole-3-acetic Acid, Plant Growth Promoting Rhizobacteria, Siderophore서 언
한약재 천궁 (Cnidii Rhizoma)은 산형과 (Umbelliferae)에 속하는 여러해살이풀로 중국천궁 (Ligusticum chuanxiong Hort), 일천궁 (Cnidium officinale Makino) 등 2 종을 기원 식물로 한다 (MFDS, 2013).
일천궁은 중국에서 들여온 재배식물로 염색체 불화합성으로 꽃이 거의 피지 않는다 (Song et al., 2009). 반면, 토천궁은 우리나라 재래종으로 꽃이 피고, 일천궁에 비해 초장이 크며 줄기가 굵으며 (Kim et al., 2015), 뿌리나 근경은 건조한 후 약용으로 사용한다. 일천궁의 근경은 진경, 진정, 혈압강하, 혈관확장, 항균, 항진작용, 그리고 비타민 E 결핍증 치료 등의 효능이 있다 (Lee et al., 2002). 최근 연구 결과에 따르면 천궁의 지상부 또한 천연 항산화제, 향장용품 및 미용용품 개발에 활용 가능한 자원으로 효용 가치가 높을 것으로 예상된다 (Oh et al., 2010).
일천궁의 국내 재배 적지로는 산간 또는 해발 400 m 내외의 준고랭지로 일교차가 크고, 최고기온이 28℃ 이하이며, 약간 음지에서 잘 자란다 (Kim et al., 2012). 또한 배수가 양호하고 보수력이 좋고 비옥한 토양이 적합하다. 우리나라에서는 경북 북부지역 (영양, 봉화)과 강원 남부지역 (태백, 삼척)이 이에 속한다 (Kim et al., 2020)
식물 내생 미생물은 식물체 내에 거주하며 식물체에 유익하거나 해로운 영향을 주지 않는 미생물을 말한다. 역사적으로, 내생 미생물은 식물 병원체로 생각되어 왔지만 최근 연구에서는 식물 생장 촉진 및 식물 병원체 및 기생충에 대한 내성 증가와 같은 숙주 식물에 대한 유익한 효과가 있는 것으로 보고되었다 (Hallmann et al., 1997). 이렇게 식물 생장을 촉진하고 질병으로부터 식물을 보호할 수 있는 식물 내생 미생물을 PGPR (plant growth promoting rhizobacterium)이라고 한다.
인 (P)은 식물 생장에 중요한 다량 영양소 중 하나이다 (Santana et al., 2016). 하지만 대부분의 인산염은 토양에서 불용성 철, 알루미늄 및 인산칼슘으로 존재한다. 불용성 인산을 가용화하기 위하여 일반적으로 인이 포함된 비료를 사용하나 화학 비료의 인산염은 반응성이 매우 높고 빠르게 고정되기 때문에 식물의 접근이 어렵고, 장기간 화학 비료를 사용할 경우 토양산성화, 수질 오염 등을 유발한다. 따라서 식물에 대한 토양 불용성 인산염의 이용률을 높이는 것이 중요하다 (Timofeeva et al., 2022).
PGPR은 다양한 메커니즘을 통해 식물과 밀접한 관계를 맺는 가뭄이나 고온과 같은 비생물적 스트레스에 대한 내성이나 생물학적 질소 고정, 불용성 인산의 가용화, ACC deaminase 활성, siderophore, hydrogen cyanide (HCN) 및 phytohormone 생성과 같은 식물 생육 증진 특성을 가진다 (Bhattacharyya and Jha, 2012). 또한, PGPR은 농업이나 임산물 분야에서 생산 비용과 화학 비료로 인한 환경 오염을 줄임으로써 효율성을 높일 수 있어 식물체 접종원으로 사용된다 (de Souza et al., 2015).
일천궁은 높은 일사와 고온에 의해 생육저해가 발생하고 특히 잎 두께가 얇아 환경요인에 대해 저항성이 낮다 (Kim et al., 2013). 최근 기후 온난화로 인하여 우리나라의 연평균 기온이 상승함에 따라 천궁의 재배면적 및 생산량이 각각 2011년 219 ㏊, 2,344 M/T (metric ton)에서 2020년 133 ㏊, 1,104 M/T 수준으로 감소하는 추세이다 (MARFA, 2021).
이러한 일천궁의 재배면적 및 생산량 감소와 관련하여 Kim 등 (2020)은 일천궁 초작과 연작 재배지의 토양 이화학성과 토양세균군집 연구를 진행하여 연작장해의 원인을 규명하고자 하였다. 또한 Kim과 Jeong (2022)은 일천궁의 지속적이고 안정적인 생산을 위하여 조직배양 방법에 관하여 연구하였다. 하지만 일천궁 재배에 유용미생물을 활용한 연구사례는 전무한 실정이다.
따라서 본 연구는 국내에서 재배 중인 일천궁의 종근으로부터 분리한 식물 내생 미생물을 이용하여 indole-3-acetic acid (IAA) 생성능, 불용성 인산의 가용화, siderophores 생성능과 같은 식물 생육 증진 능력을 검정하고 일천궁 작물에 적용하여 생육 증진능의 효과를 구명하고자 하였다.
재료 및 방법
1. 미생물 선발 및 동정
우리나라 일천궁 재배지 중 대표적인 지역인 강원도 정선과 태백, 충청북도 제천 지역에서 생육 상태가 우수한 일천궁 (C. officinale Makino)을 채집하였다. 채집한 일천궁 종근의 표면을 흐르는 물로 깨끗이 씻어 표면의 흙을 제거한 뒤 일정한 크기로 잘라 멸균 증류수에 넣고 27℃에서 72 시간 동안 미생물을 배양하였다.
천궁 내생 미생물을 분리하기 위하여 배양액 tryptic soy agar (TSA, KisanBio, Seoul, Korea), nutrient agar (NA, KisanBio, Seoul, Korea), luria-bertani agar (LB Agar, KisanBio, Seoul, Korea) plate에 평판 도말하여 3 일간 39℃에서 배양하여 순수분리하였다.
순수분리된 균주들 중 생육증진능이 우수한 균주를 선발하기 위하여 식물호르몬 (IAA) 생성능을 조사하였다. L-tryptophan 배지 (Gelatin pancreatic peptone 10 g, NaCl 5 g, L-tryptophan 1 g/ℓ dH2O, pH 7.5 at 25℃) 9 ㎖에 순수분리 균주들을 TSB 배지에 접종하여 27℃에서 24 시간동안 배양한 미생물 배양액 1 ㎖를 접종하여 27℃에서 배양하 며 24 시간마다 IAA 생성을 측정하였다. 실험 결과 IAA 생성능이 가장 우수한 균주를 최종 선발하였고 IAA 생성능이 가장 부진한 균주를 positive control로 선정하였다.
최종 선발된 균주의 16s rRNA 분석 진행 후 얻은 sequence는 NCBI (https://www.ncbi.nlm.nih.gov/) BLASTN 검색프로그램을 이용하여 등록 균주와 유사성을 비교하였고 MEGA 11 프로그램 (Molecular Evolutionary Genetics Analysis, Pennsylvania State University, State College, PA, USA)을 이용하여 계통도를 작성하였다.
2. 온도에 따른 분리 균주의 생장 조건 분석
분리된 균주의 최적 생장 온도를 분석하기 위해 분리 균주를 TSB 배지에 접종한 뒤 optical density (OD)가 600 ㎚에서 0.1이 되도록 보정하였다. 보정된 배양액 1 ㎖를 TSB 배지 9 ㎖에 접종한 후 0℃ - 40℃ 에서 5℃ 간격으로 5 일간 진탕 배양하였다. 24 시간 간격으로 UV-Vis Spectrophotometer (Ubi-490, MicroDigital Co., Ltd., Seongnam, Korea)를 이용해 OD600 값을 측정하여 분리 균주의 생장 정도를 확인하였다.
3. Indole-3-acetic acid (IAA) 생성능 조사
식물 호르몬인 IAA 생산능 평가를 위해 L-tryptophan 배지 (Gelatin pancreatic peptone 10 g, NaCl 5 g, L-tryptophan 1 g/ℓ dH2O, pH 7.5 at 25℃) 배지 9 ㎖에 미생물 배양액 1 ㎖를 접종하여 27℃에서 배양하며 24 시간마다 선발 균주와 positive control 균주 배양액의 1 ㎖를 4℃에서 원심분리하여 상등액을 분리하였다. Positive control은 T13 균주를 사용하였다.
분리한 상등액은 Salkowski’s reagent (35% HClO4 98 ㎖, 0.5 M FeCl3 2 ㎖) 2 ㎖와 각각 혼합하고 빛이 없는 상온에서 30 분간 반응시킨 뒤 UV-Vis Spectrophotometer (Ubi-490, MicroDigital Co., Ltd., Seongnam, Korea)를 이용하여 OD535를 측정하였다. 측정값은 IAA (Duchefa Biochemie, Haarlem, Netherlands) 표준물질을 사용하여 만든 표준곡선을 이용하여 정량하였다.
4. 인산가용화능(Phosphate solubilizing) 조사
미생물의 인산가용화능을 조사하기 위해 national botanical research institute’s phosphate growth agar (NBRIP agar, glucose 10 g, Ca3(PO4)2 5 g, MgCl2·6HSO 5 g, MgSO4·7H2O 0.25 g, KCl 0.2 g and (NH4)2SO4 0.1 g, bacto agar 15 g, distilled water 1 ℓ) 배지에 선발 균주와 T13 균주 배양액 3 ㎕를 접종한 paper disc를 얹고 27℃에서 배양하였다. 4 일 후 paper disc 주변의 clean zone 형성 유무를 확인하였다 (Nautiyal, 1999).
5. Siderophore 생성능 조사
미생물의 siderophore 생성능을 조사하기 위해 chrome azurole S (CAS) blue agar plate assay 이용하였다. 60 ㎎의 chrome azurole S (CAS) 를 50 ㎖의 증류수에 녹인 후 10 ㎖의 iron (Ⅲ) solution (1 mM FeCl3·6H2O and 10 mM HCl)과 섞었다. 섞은 solution을 자력교반기 (SMHS-3, DAIHAN Scientific, Wonju, Korea)로 저어가며 72.9 ㎎ HDTMA를 녹인 40 ㎖의 증류수를 첨가한 뒤 고압 멸균하였다.
750 ㎖ dH2O, 10 × MM9 salts, 15 g agar, 30.24 g Pipes, 12 g 50 % (w/w) NaOH solution 혼합물 또한 고압 멸균한 뒤, Pipes는 50℃로 냉각한 후 30 ㎖의 casamino acid (10%) 를 멸균 용액으로 첨가하였다. CAS plate에 분리된 균주와 T13 균주 배양액을 3 ㎕를 접종한 paper disc를 각각 얹고 27℃에서 배양하였다. 4 일 뒤 orange halo zone 형성 유무를 확인하였다 (Schwyn and Neilands, 1987)
6. 생화학적특성 조사
균주가 분비하는 효소의 특성 분석을 위해 API ZYM kit (Biomérieux, Craponne, France)를 이용하였다. 제품 매뉴얼에 따라 TSB 배지에서 27℃, 1일간 배양한 선발 미생물을 등장액 (suspension solution)에 접종하여 5 - 6 McFarland로 탁도를 맞춘 뒤 각 cupule에 65 ㎕ 씩 분주하였다. 37℃에서 4시간 동안 배양한 후 ZYM A와 ZYM B 시약을 큐플에 한 방울씩 떨구고 5 분간 기다린 후 결과를 판독하였다.
7. 식물생장촉진 미생물 생물검정
천궁 내생미생물을 대상으로 식물 생육증진 효과를 확인하기 위하여 포트실험을 진행하였다. 고압 멸균한 원예용상토 (Han Areum, Goesan, Korea)가 담긴 포트 (8.5 ㎝ × 8.5 ㎝ × 9 ㎝)에 8 – 10 g의 천궁 종근을 심어 실험하였다. 실험은 L2 균주에 의한 일천궁 생육 증진의 가능성을 알아보기 위하여 무처리 대조군 (control), 토양 접종 실험군 (soil inoculation), 그리고 종근 접종 실험군 (rhizoma inoculation) 로 진행하였다.
미생물은 TSB 배지에서 72 시간 배양한 배양액을 원심분리하여 상등액을 제거한 후 OD600이 0.1이 되도록 증류수에 희석하여 각 처리 당 50 ㎖씩 준비하였다. 토양 접종 실험은 천궁 종근 주변 토양에 준비한 증류수 희석액을 접종하였다. 종근 접종 실험은 천궁 종근을 직접 증류수 희석액에 3 시간 정도 담가둔 후 다시 pot에 심었다. 접종은 7 일 간격으로 3회 처리하였고 실험은 처리 당 10 개씩 실시하였다. 3 일마다 관수하며 5 주간 20 ± 1℃, 광조건하에서 (80 μ㏖·m-2·s-1, 주백색 형광등, 16 시간) 재배한 후 처리된 천궁을 대상으로 지상부 길이와 잎의 개수, 지상부와 지하부의 생중량, 건중량을 측정하였다.
8. 데이터 분석
실험 결과분석을 위한 통계는 SPSS v.25.0 (IBM Co., Armonk, NY, USA)를 이용하여 일원배치 분산분석 (One-way ANOVA)을 실시하였고 5% 유의수준에서 Duncan’s Multiple Range Test (DMRT)로 유의성을 검증하였다 (p < 0.05).
결과 및 고찰
1. 미생물 선발 및 동정
생육증진 내생미생물을 선발하기 위해 강원도 정선, 강원도 태백, 충청북도 제천 각 지역에서 8 균주, 12 균주, 4 균주를 분리하여 총 24 균주를 확보하였다. 생육 증진능이 우수한 균주를 선발하기 위하여 분리한 균주를 대상으로 식물호르몬 (IAA) 생성능을 조사하였다 (Table 1).

Bacterial isolates from Cnidium officinale Makino rhizosphere and their plant growth promoting rhizobacteria effect.
그 결과, 충천북도 제천에서 채집한 천궁에서 분리한 L2 균주가 IAA 생성능이 가장 우수한 것을 확인하여 최종 선발하였다. 또한, IAA 생성능이 가장 부진한 T13 균주를 식물생육증진능에 대한 연구에 사용할 positive control로 선정하였다. L2 균주를 16s rRNA로 동정한 결과 Enterobacter ludwigii와 99%의 염기서열 유사도를 나타냈다 (Fig. 1).
Phylogenetic tree based on 16s rRNA sequences of strain L2.Phylogenetic tree was constructed based on 16s rRNA sequences by the neighbor-joining method using MEGA v11 program. The numbers at the nodes are bootstrap values greater than 50% with 1000 bootstrap replications. GeneBank accession numbers of the sequences are indicated in parentheses. Serratia bozhouensis and Serratia microhaemolytica are used as out-group. Bold letters represent the isolate names of sequences determined in this study.
2. 온도에 따른 분리 균주의 생장조건 분석
분리 균주의 최적 생장 온도 분석을 위해 24 시간 간격으로 생장 정도를 측정한 결과, L2 균주는 15℃에서 활력이 가장 뛰어난 것을 확인하였다. 또한 15℃부터 40℃ 사이에선 L2 균주가 배양 시작 후 하루 동안 가장 급격한 생장을 보인 반면 10℃에선 배양 시작 이틀 후 가장 급격한 생장을 보였다. 그리고 10℃부터 30℃ 사이에서 L2 균주가 시간이 지남에 따라 계속해서 성장하는 추세를 보인 반면 40℃ 이상에서는 72시간이 지나며 생장을 멈추고 활력이 급격히 떨어지는 것을 확인하였다. 따라서 L2 균주는 10℃에서 30℃ 사이에서 활발히 생장하며 생장 최적 온도는 15℃인 것을 확인하였다 (Fig. 2).
일천궁은 여름철 최고기온이 28℃ 이하의 서늘한 준고랭지에서 주로 재배되고 있고 이는 L2 균주가 활발히 생장하는 온도인 30℃와 유사하다. 따라서 L2 균주를 실제 미생물 제제로 사용할 때, 일천궁 재배지에 접종할 때, 균주의 활력을 유지할 수 있을 것으로 사료된다.
3. Indole-3-acetic acid (IAA) 생성능 조사
식물 생육 증진 호르몬 생성 여부를 확인하기 위해 생육 증진 효과가 우수한 L2를 대상으로 IAA 생성능을 조사하였다. 그 결과, 5 일의 배양 기간 동안 IAA 생성능을 나타내었고, 배양 기간이 길수록 많은 IAA를 생성하는 것을 확인하였다 (Fig. 3, Table 2). IAA를 가장 많이 생성하는 배양 5 일차에 는 L2 균주가 60.45 ㎍/㎎으로 positive control인 T13 균주와 확연한 차이를 보였다.
IAA productions by bacterial isolates L2 and positive control (T13).Vertical bars mean standard deviations (n = 3).
4. 인산가용화 (phosphate solubilizing) 활성
분리한 천궁내생미생물을 대상으로 불용성 인산을 가용화 할 수 있는지 확인하기 위해 NBRIP 평판배지를 활용하여 인산가용화 실험을 진행하였다. 실험 결과 T13 배양액을 접종한 paper disc 주변엔 clear zone이 형성되지 않았지만 L2 배양액을 접종한 paper disc 주변에 clear zone이 관찰되어 L2 균주는 불용성 인산을 가용할 수 있는 것으로 판단하였다 (Fig. 4).
5. Siderophore 생성능 조사
철은 필수 미량 영양소이며 식물에서 철은 광합성, 호흡, 질소 고정 및 DNA 합성과 같은 일부 중요한 생리학적 활동 및 산화·환원반응에 필요하다 (Briat et al., 1995). 철은 토양 내에 풍부하게 존재하지만, 불용성으로 인해 식물은 철분 결핍상태가 되기 쉽고 이는 작물 생산의 품질과 양을 크게 감소시킨다 (Pahari et al., 2018). Siderophore는 토양에 자연적으로 존재하는 불용성 철에 대한 가용화를 촉진함으로써 식물성장을 돕는 역할을 한다 (Magdalena et al., 2019).
천궁 내생 미생물의 CAS agar를 사용하여 siderophore 생성능을 확인한 결과, T13 균주는 siderophore를 생성하지 않았지만 L2 균주는 siderophore를 생성하는 것을 확인하였다 (Fig. 5).
6. 생화학적 특성 조사
분리된 균주의 생화학적 특성을 확인하기 위해 API ZYM kit를 이용하여 측정하였다. 측정 결과, L2는 Alkaline phosphatase, Leucine arylamidase, Acid phosphatase, Naphtol-AS-BI-phosphohydrolase, β-glucuronidase, β-glucosidase에 대해서 양성반응을 보였다 (Table 3). 특히 API ZYM kit에서 세포 대사 유지를 위한 무기 인산염의 공급 및 대사에 중요한 역할을 하는 Alkaline phosphatase (Fajana et al, 2013)와 주변 환경에 존재하는 무기 인산염의 가용성을 증가시키는 것에 도움을 주는 Acid phosphatase (Wang and Liu, 2021) 활성에 양성반응을 보여 L2 균주는 불용성 인산을 가용화시키는 효소 활성을 지닌 미생물로 판단된다. 따라서 L2 균주는 식물생장에 필수적인 인 (P)의 가용화를 도와주는 효소를 지닌 균주로 미생물 제제로서 유용하게 사용될 것으로 기대된다
7. 식물생장촉진 미생물 식물검정
천궁에서 분리한 유용 내생 미생물의 식물 생육 증진 가능성을 식물체에서 검증하기 위해 5 주간 소규모 pot 재배 실험을 진행하였다.
실험 결과, 잎의 길이를 제외한 모든 항목에서 토양 접종 실험군이 무처리구와 구근 접종 실험군에 비하여 생육이 우수한 것을 확인하였다. 특히, 식물체의 잎의 개수, 구근 생중량 그리고 지상부 건중량에서는 유의미한 차이를 확인할 수 없었으나, 지상부 생중량과 구근 건중량에서 토양 접종 실험군이 무처리구에 비하여 각각 141.44%와 28.04%로 유의한 수준 (p < 0.05)으로 증가하였다 (Table 4).
포트 재배 실험을 통하여 구근을 직접 증류수 희석액에 담갔다 빼는 접종 방법은 뿌리 활착이 불안정하여 토양 접종 방법에 비하여 생육이 부진하였다고 판단되었다. 따라서 포장적용실험을 통해 주변 환경에 따라 효과적인 미생물 접종을 위하여 미생물 희석액의 최적 농도를 파악하고 토양 접종 방법을 어떻게 시행할 것인지 추가 연구가 필요하다.
식물생육증진능이 있는 천궁 내생 미생물을 분리하기 위해 식물호르몬 생성능이 우수한 균주를 선발하여 16s rRNA 염기서열 분석 결과 선발 균주 L2는 Enterobacter ludgiwii와 높은 서열 유사성을 나타내었다
Shoebitz 등 (2009)의 연구에서 호르몬 생성능과 미네랄 가용화, 항진균능 검정 실험을 통해 E. ludwigii의 PGPR 기능을 처음 제시하였다. Dolkar 등 (2018)은 E. ludwigii 가 각종 온도나 염분 스트레스에 강한 내성을 가지는 균주로 보고하였다. 최근 연구에서 Lee 등 (2019)은 E. ludwigii가 특히 불용성 인산 가용화 효과가 뛰어나다는 연구 결과를 보고하였고 Wang 등 (2020)의 연구에서는 오염 토양에서 중금속 저항균주로서의 가능성을 제시하였다.
또한 식물생육증진능 그리고 소규모 재배 실험 결과 L2 균주는 천궁의 생육증진에 효과가 있음을 확인하였다. 이는 분리 균주인 L2에 의한 IAA 생성능, siderophore 생성능, 인산가용화능에 의한 것으로 사료된다. 따라서 L2 균주를 실제 천궁 재배 토양에 적용하였을 때 천궁의 생육을 증진시키고, 향후 미생물 천연비료로서 활용될 가능성이 존재한다. 그러나 소규모 재배 실험은 실제 천궁 재배지 환경과 상이하므로 분리균주의 적용이 다양한 환경적 요인에 따라 천궁 생육에 어떤 영향을 미치는지, 접종 전 천궁 재배 토양에 존재하는 미생물과 어떻게 상호작용하는지에 대한 현장 재배 연구가 진행되어야 할 것이다.
Acknowledgments
본 연구는 정부(과학기술정보통신부)의 재원으로 한국연구재단(과제번호: 2020R1F1A1054290) 및 산림청(한국임업진흥원) 산림과학기술 연구개발사업(과제번호: FTIS 2019149C10-2323-0301)의 지원에 의하여 이루어진 것으로 이에 감사드립니다.
References
-
Albelda-Berenguer M, Monachon M and Joseph E. (2019). Siderophores: From natural roles to potential applications. Advances in Applied Microbiology. 106:193-225.
[https://doi.org/10.1016/bs.aambs.2018.12.001]
-
Bhattacharyya PN and Jha DK. (2012). Plant growth-promoting rhizobacteria (PGPR): Emergence in agriculture. World Journal of Microbiology and Biotechnology. 28:1327-1350.
[https://doi.org/10.1007/s11274-011-0979-9]
-
Briat JF, Fobis-Loisy I, Grignon N, Lobréaux S, Pascal N, Savino G, Thoiron S, von Wirén N and van Wuytswinkel O. (1995). Cellular and molecular aspects of iron metabolism in plants. Biology of the Cell. 84:69-81.
[https://doi.org/10.1016/0248-4900(96)81320-7]
-
de Souza R, Ambrosini A and Passaglia LM. (2015). Plant growth-promoting bacteria as inoculants in agricultural soils. Genetics and Molecular Biology. 38:401-419.
[https://doi.org/10.1590/S1415-475738420150053]
- Fajana OO, Adu OB, Ogunrinola OO, Olaitain SN, Raimi OG, Ebenezer OA and Elemo BO. (2013). Characterization of alkaline phosphatase(E.C 3.1.3.1) from the seeds of Dacryodes edulis(African Pear) a likely industrial source for enzyme production. The International Journal of Engineering and Science. 2:31-36.
-
Hallmann J, Quadt-Hallmann A, Mahaffee WF and Kloepper JW. (1997). Bacterial endophytes in agricultural crops. Canadian Journal of Microbiology. 43:895-914.
[https://doi.org/10.1139/m97-131]
-
Kim DH, Park JM, Kang SM, Lee SM, Seo CW, Lee IY and Lee IJ. (2015). Distribution characteristics of weeds and vegetation types in Cnidium officinale field. Weed and Turfgrass Science. 4:279-287.
[https://doi.org/10.5660/WTS.2015.4.4.279]
- Kim J, Jang W, Kim S and Park J. (2012). General information, cultivars and characteristics. Easy guide to understanding cultivation of Cnidium officinale Makino and Ligusticum chuanxiong Hort. Bongwha Highland Medicinal Plants Experiment Station. Bonghwa, Korea. p.8-30.
-
Kim JA and Jeong HY. (2022). Regeneration of plant according to somatic embryogenesis types in Cnidium officinale Makino. Korean Journal of Medicinal Crop Science. 30:204-209.
[https://doi.org/10.7783/KJMCS.2022.30.3.204]
-
Kim KY, Han KM, Kim HJ, Jeon KS, Kim CW and Jung CR. (2020). The study of soil chemical properties and soil bacterial communities on the cultivation systems of Cnidium officinale Makino. Korean Journal of Environmental Agriculture. 39:1-9.
[https://doi.org/10.5338/KJEA.2020.39.1.1]
-
Kim KY, Han KM, Kim HJ, Kim CW, Jeon KS and Jung CR. (2020). Effect of soil properties on soil fungal community in first and continuous cultivation fields of Cnidium officinale Makino. Korean Journal of Medicinal Crop Science. 28:209-220.
[https://doi.org/10.7783/KJMCS.2020.28.3.209]
-
Kim YS, Kim SW, Lamsal K and Lee YS. (2016). Evaluation of rhizobacterial isolates for their antagonistic effects against various phytopathogenic fungi. Korean Journal of Mycology. 44:36-47.
[https://doi.org/10.4489/KJM.2016.44.1.36]
- Lee JH, Choi HS, Chung MS and Lee MS. (2002). Volatile flavor components and free radical scavenging activity of Cnidium officinale. Korean Journal of Food Science and Technology. 34:330-338.
- Ministry of Agriculture, Food and Rural Affairs(MAFRA). (2021). 2020 an actual output of crop for a special purpose: Annual production data of medicinal crops. Ministry of Agriculture, Food and Rural Affairs. Sejong, Korea. p.103-106
- Ministry of Food and Drug Safety(MFDS). (2013). The Korean pharmacopoeia. Ministry of Food and Drug Safety. Cheongju, Korea. p.1267
- Nautiyal CS. (1999). An efficient microbiological growth medium for screening phosphate solubilizing microorganisms. FEMS Microbiology Letters. 170:265-270.
- Oh YJ, Seo HR, Choi YM and Jung DS. (2010). Evaluation of antioxidant activity of the extracts from the aerial parts of Cnidium officinale Makino. Korean Journal of Medicinal Crop Science. 18:373-378.
- Pahari A, Pradhan A, Nayak SK and Mishra BB. (2017). Bacterial siderophore as a plant growth promoter. In Patra J. et al. (ed.). Microbial biotechnology. Springer. Singapore, Singapore. p.163-180.
- Rijavec T and Lapanje A. (2016). Hydrogen cyanide in the rhizosphere: Not suppressing plant pathogens, but rather regulating availability of phosphate. Frontiers in Microbiology. 7:1785. https://www.frontiersin.org/articles/10.3389/fmicb.2016.01785/full, (cited by 2022 April 22).
- Santana EB, Marques ELS and Dias JCT. (2016). Effects of phosphate-solubilizing bacteria, native microorganisms, and rock dust on Jatropha curcas L. growth. Genetics and Molecular Research. 15:15048729. chrome-extension://efaidnbmnnnibpcajpcglclefindmkaj/ https://www.geneticsmr.com/sites/default/files/articles/year2016/vol15-4/pdf/gmr8729.pdf, (cited by 2022 Sep 27).
- Schippers B, Bakker AW, Bakker PAHM and Van Peer R. (1990). Beneficial and deleterious effects of HCN-producing pseudomonads on rhizosphere interactions. Plant and Soil. 129:75-83.
- Schwyn B and Neilands JB. (1987). Universal chemical assay for the detection and determination of siderophores. Analytical Biochemistry. 160:47-56.
- Song IG, An BR, Seo BI and Park SJ. (2009). Molecular marker to identify and origin of Cnidii Rhizoma from Korea and China. Korea Journal of Herbology. 24:1-8.
- Timofeeva A, Galyamova M and Sedykh S. (2022). Prospects for using phosphate-solubilizing microorganisms as natural fertilizers in agriculture. Plants. 11:2119. https://www.mdpi.com/2223-7747/11/16/2119, (cited by 2022 Sep 27).
- Wang L and Liu D. (2012). Arabidopsis purple acid phosphatase 10 is a component of plant adaptive mechanism to phosphate limitation. Plant Signaling and Behavior. 7:306-310.
- Yoo JY, Jang EJ, Park SY and Son HJ. (2018). Production of HCN, weed control substance, by Pseudomonas koreensis and its plant growth-promoting and termiticidal activities. Journal of Environmental Science International. 27:771-780.